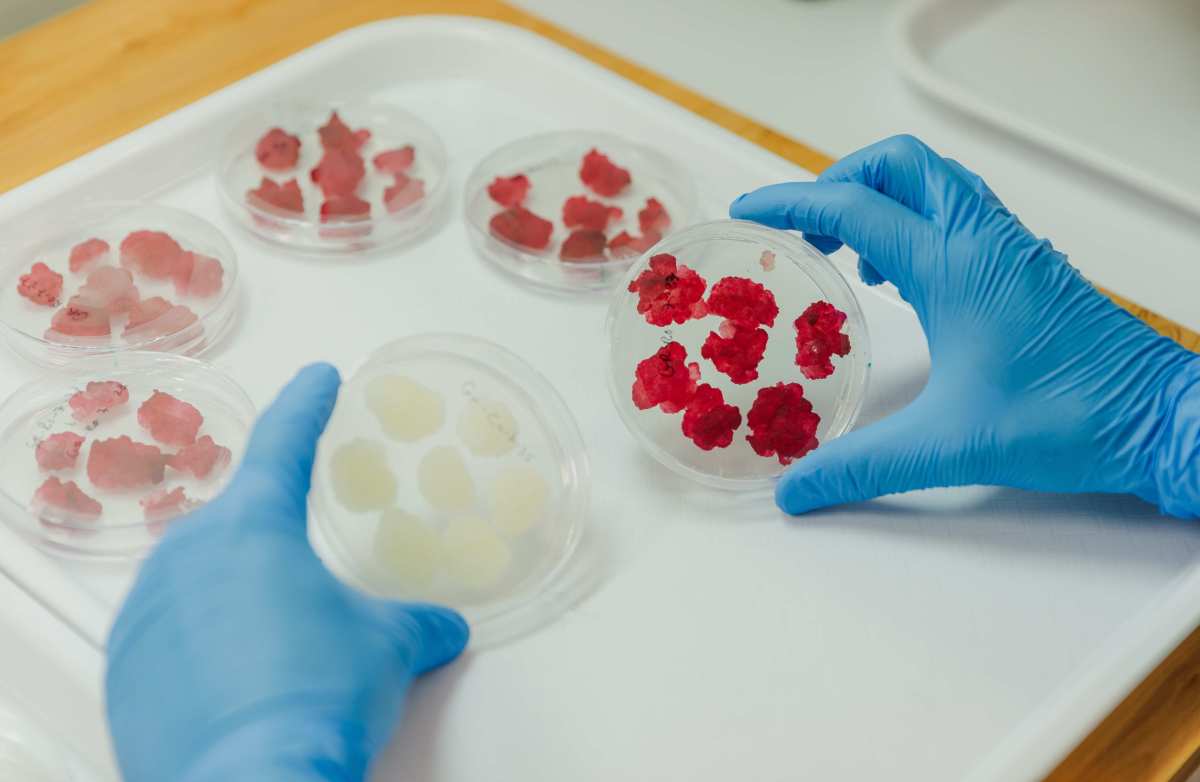

Novella Innovative Technology, Ltd., an innovator in plant-cell-based ingredients, announces the appointment of Antonio Martinez Descalzo, a global expert in scaling health and wellness ingredients as company CEO. The biotech and nutrition veteran will lead the start-up’s transition from its intensive R&D phase toward full-scale commercial operation.

Martinez brings more than two decades of global leadership experience in the life sciences, health, and nutraceutical industries. He previously held several senior leadership roles at the food and beverage giant ADM, including Vice President of Innovation and Business Development Director for its health and wellness division where he was a key architect in promoting branded ingredients across international markets.Martinez is particularly experienced in the probiotics and specialty ingredients sector, having contributed his strategic vision to the Board of Directors of the International Probiotics Association (IPA).
“2026 marks a pivotal operational year for Novella,” states Kobi Avidan, Chairman and co-founder of Novella. “Having successfully completed pilot production, we are moving into full industrial manufacturing, responding to the global demand for precise, consistent, and high-potency botanical ingredients. Martinez’s combined background as a seasoned nutraceutical expert and global commercial strategist makes him the ideal leader to steer Novella toward becoming a commercial powerhouse.”
Novella’s development of AuraCell™ technology is opening a new era in nutraceutical sourcing. The breakthrough precision-cultivation platform enables the growth of bioactive botanical compounds directly from plant cells in a closed, controlled environment, bypassing the need to grow the whole plant. Beyond slashing resource use, the platform delivers pure, high value, standardized phytonutrients with guaranteed consistency and zero waste.
Last year, Novella launched its first creation: Novella Strawberry∞, a uniquely potent whole-cell strawberry ingredient, which embodies the natural synergy of strawberry’s lauded compounds, including antioxidant phenolic acids, and others. The product is available for industrial validation and sampling.
Precision Botanicals: the new category for nutraceuticals
“We’re introducing the new category of ‘Precision Botanicals’ into the nutraceutical space,” declares Martinez. “It’s a sustainable channel that will deliver fully standardized botanical ingredients at consistent volumes in line with regulatory and consumer requirements. Novella’s breakthrough technology reinforces the fragile supply chains for botanical extracts, which are seeing a reemergence in demand for their potent antioxidant power and relevance to broad wellness channels. This will also bring more price stability via protection from global climate fluctuations.”
New Partnerships
Over the last year, commercial production of Novella Strawberry∞ has been moving into full swing at the Italian state-of-the-art facilities of Chemo Biosynthesis, Srl, the industrial division of Insud Pharma Group, S.L.. Chemo specializes in providing contract development and manufacturing organization (CDMO) services for the pharmaceutical sector.

In a strategic contract-manufacturing partnership, Chemo is integrating Novella’s proprietary technology into its processes. This will enable Novella to meet commercial demands of tons of Novella Strawberry∞, at the highest standards of quality, safety, and purity.
“Beyond the advantages of having a lean production model that does not require capital-intensive facility build-outs, this approach enables the production of natural ingredients at volume with pharmaceutical-grade precision,” adds Martinez.
Commercial roll-out of Strawberry∞ is projected for 2027, with the North American USD60 billion valued nutraceutical industry on Novella’s initial market radar. Other Novella whole-cell ingredients are also in the pipeline for release.
Parallel to its commercial launch, Novella is aggressively strengthening its developmental and operational core through partnerships with other world-class CDMOs, including CPI (Centre for Process Innovation), a renowned provider of process development, scale-up, and biomanufacturing services and Extracellular Ltd., a leading CDMO dedicated to the scale-up and development of cultivated products. This will enhance its upstream and downstream production processes.
In January 2026, Novella received grant approval from the EIT (European Institute of Innovation and Technology) to strengthen the development of downstream processing for plant cell culture under a specific biotech innovation call. This prestigious grant, awarded in collaboration with Extracellular, acknowledges Novella’s cultivation methods as a leading example of sustainable innovation in Europe, ensuring that production processes are both economically viable and environmentally sustainable.
“These combined efforts, and the introduction of Martinez into the Novella team, will create a robust, multi-layered ecosystem that supports Novella’s goal of disrupting the traditional nutraceutical supply chain. We look forward to advancing from the start-up stage to a full-production company,” Avidan concludes.
About Novella
Novella Innovative Technology is a biotechnology company pioneering fruit- and vegetable-derived cell complexes for clean, intelligent, and sustainable wellness solutions. Leveraging its proprietary AuraCell™ platform, Novella delivers whole-cell plant ingredients that preserve full-spectrum bioactivity, driving the next generation of supplement innovation.